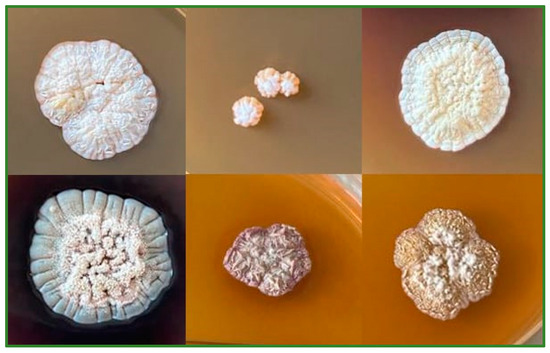

Abstract
The objective of this study was to isolate and characterize actinobacteria from the rhizosphere of medicinal and aromatic plants, specifically lavender (Lavandula angustifolia Mill.), lemon balm (Melissa officinalis L.), and oregano (Origanum vulgare L.). Rhizospheric soil samples revealed a high abundance of culturable actinobacteria (6.97–7.23 log10 CFU/g). Six isolates were selected for their promising enzymatic activities (lignin peroxidase, carboxymethyl cellulase) and antimicrobial properties. Isolates M345 and M162 exhibited the highest cellulase activity indices (3.19 ± 0.71 and 2.54 ± 0.22, respectively), with five isolates producing lignin peroxidase. These actinobacteria also demonstrated plant growth-promoting traits such as phosphate solubilization and nitrogen fixation, along with strong antimicrobial activity against Gram-negative bacteria and phytopathogenic fungi. Additionally, they significantly enhanced maize seed germination, increasing the vigor index from 4283.33 ± 1264.37 to 6248.28 ± 1661.94 compared to that of the control. These results indicate that the isolated actinobacteria strains hold potential as microbial inoculants for sustainable agriculture, contributing to soil health, plant growth, and pathogen management.
1. Introduction
The demand for food has been continuously increasing in regards to both quality and quantity [1], yet current agro-industrial productivity is constrained by factors such as soil deterioration, depletion of beneficial microbes, and the spread of pathogens [2,3,4,5,6]. To address these challenges, various soil management techniques are now available that aim to mitigate degradation processes and ensure adequate, accessible, and affordable food supplies [1]. Intensified agricultural practices have led to the accumulation of plant residues, with over 5 × 1010 metric tons of plant polymers generated each year [7]. These residues are often managed in situ (e.g., through incorporation) to reduce nutrient loss, enhance soil structure, and promote biological activity. However, their high carbon-to-nitrogen ratio, along with significant lignin, cellulose, and hemicellulose content, can impede the biodegradation of retained waste and affect the physical, chemical, and biological properties of the soil [8,9,10]. Soil-dwelling microbes play a primary role in the degradation of these polymers [7]. As part of precision management strategies [11], microbial biofertilizers are increasingly used in agro-industry to improve soil quality, nutrient cycling, and crop productivity [3]. Enriching the rhizosphere with beneficial microbes can enhance disease suppression [12], while microbial assistance in residue management accelerates plant material decomposition, thereby improving overall soil ecosystem functions. However, the selection of an appropriate microbial consortium is essential for effective crop residue degradation and efficient nutrient cycling [9].
Among beneficial microbes, actinobacteria species hold significant biotechnological and economic importance in agro-industry by promoting plant growth, facilitating organic matter recycling, and shaping soil microbial communities [3,13]. These Gram-positive bacteria are characterized by a high genomic G + C content in their DNA. They are ubiquitous in nature, widely distributed across various ecosystems, and some species possess the ability to form resistant exospores, enabling them to survive in highly competitive environments [3,14,15,16,17]. Additionally, through the production of various agroactive compounds, actinobacteria contribute to biopolymer degradation, act as biocontrol agents against pathogens, and enhance plant development [18]. As a result, they are ideal candidates for the development of agricultural products with significant benefits.
Numerous studies have explored the potential of actinobacteria in developing new inoculants for waste treatment and soil health improvement [19]. Medicinal and aromatic plants represent a significant segment of the economy, providing valuable raw materials such as botanicals and organic amendments, as well as microbes that contribute to agricultural sustainability [20,21,22]. The rhizosphere of these herbs acts as a rich reservoir of bacterial consortia with potential biocontrol properties [23]. The diversity of the microbiota surrounding their roots may be influenced by secondary metabolites, root exudates, and root litter [20,24]. Plants in the Lamiaceae family, known for their antimicrobial properties, have gained commercial importance. The rhizosphere of these herbs is often dominated by actinobacteria, which produce enzymes, antibiotics, phytohormones, and other bioactive compounds [25]. Despite their potential, these ecosystems remain relatively unexplored in terms of actinobacteria isolation.
Therefore, this research was conducted to isolate and characterize rhizospheric actinobacteria associated with the soil of medicinal and aromatic plants, including Lavandula (L.) angustifolia Mill., Melissa (M.) officinalis L., and Origanum (O.) vulgare L. Following enzymatic evaluation, six isolates were selected for the formulation of a new microbial inoculant intended to support plant growth, enhance seed germination, and improve soil health by facilitating the biodegradation of complex molecules and inhibiting the spread of pathogenic microorganisms.
2. Materials and Methods
2.1. Site Description and Sample Collection
In February 2023, five soil samples were collected from the rhizosphere beneath the canopies of L. angustifolia Mill., M. officinalis L., and O. vulgare L. at Kisalföldi Agricultural Ltd. (Nagyszentjános, Hungary), situated in northwestern Hungary (47°43′05.5″ N, 17°53′50.6″ E). This region experiences a moderately warm and dry continental climate, with an annual mean temperature ranging from 9.8 to 10.2 °C and an annual precipitation between 550 and 580 mm [26]. The medicinal and aromatic herb garden, established in 2017, spans an area of 9600 m2, with lemon balm, lavender, and oregano planted in sections of 3000 m2, 300 m2, and 300 m2, respectively. During the sampling, approximately 150 g of sub-samples were collected in sterile polyethylene bags, sealed tightly, and transported immediately to the laboratory. Upon arrival, the fresh samples were promptly plated on Nutrient Agar (Sigma-Aldrich, St. Louis, MO, USA), Rose Bengal Chloramphenicol Agar (Biolab, Budapest, Hungary), and Actinomycete Isolation Agar (AIA; Sigma-Aldrich) media to determine the total viable counts of various microbial groups, including mesophilic microorganisms, fungi (molds and yeasts), and actinobacteria.
2.2. Isolation, Purification, and Maintenance of Actinobacteria
After homogenization, the pooled soil samples were air-dried for 7 days on sterile trays to reduce the numbers of vegetative bacterial cells [27]. The dried soil was then aseptically crushed using a mortar and pestle, sieved through a 2 mm sifter, and immediately used for isolation. A total of 10 grams of dried soil was added to 90 mL of sterile saline solution (0.85% NaCl) and vigorously homogenized in a stomacher blender bag (Biolab) for 1 min using a BagMixer 400 (Interscience, Puycapel, France). Decimal dilutions were prepared up to 10−6, and aliquots of 0.1 mL from the 10−4 to 10−6 dilutions were evenly spread over the surface of AIA plates, with three replicates per dilution. To minimize contamination from fungi and Gram-negative bacteria, the medium was supplemented with 50 µg/mL nalidixic acid (Sigma-Aldrich) and 50 µg/mL cycloheximide (Biolab). The inoculated plates were incubated aerobically at 28 ± 2 °C and monitored periodically for actinobacteria growth over a 4-week period. According to methods described by Menasria et al. [28] and Niladevi et al. [29], actinobacteria were identified by the formation of filamentous hyphae, or tough, leathery colonies. Morphologically diverse colonies were selected and transferred to fresh isolation plates using the streak plate technique. Purified cultures were obtained after two to three rounds of successive sub-culturing and were preserved on Tryptic Soy Agar (TSA; Biolab, Budapest, Hungary) slants at 4 °C and in 20% glycerol solution at −70 °C for long-term storage.
2.3. Morphological, Physiological, and Biochemical Characterization of Selected Actinobacteria Isolates
The morphological and cultural characteristics of the isolates were assessed following the International Streptomyces Project (ISP) guidelines, using ISP-2, ISP-3, ISP-4, ISP-5, ISP-6, and ISP-7 media [30]. The colony characteristics were examined under a high-powered magnifying glass and noted after 14 days of incubation [31,32]. The selected strains exhibited typical actinobacterial phenotypic morphologies [33].
The pH tolerance of the strains was determined by adjusting the pH of the ISP-2 medium to values of 3, 4, 5, 6, 7, 8, 9, 10, and 11 using 0.1 M HCl or 0.1 M NaOH solutions. Drought tolerance was assessed following the method described by Lasudee et al. [34], using 10% TSA supplemented with 0, 85, 285, 405, and 520 g/L sorbitol (Fluka, Buchs, Switzerland), corresponding to water activity (aw) values of 0.998, 0.995, 0.963, 0.930, and 0.912 at 25 °C, respectively [35]. Growth observed at an aw of 0.912 was considered indicative of drought tolerance. The ability of isolates to grow at different temperatures was tested on ISP-2 Agar at 10, 20, 30, 40, and 50 °C. NaCl tolerance was evaluated by adding varying concentrations of NaCl (0–10%, w/v) to ISP-2 medium [32].
Several biochemical tests were conducted to differentiate the selected isolates, following the protocols provided by the reagent and media suppliers. These tests included Gram staining (Biolab), catalase testing (Biolab), oxidase testing (Sigma-Aldrich), urease testing (Sigma-Aldrich), nitrate reduction testing (Biolab), citrate utilization testing (Biolab), Triple Sugar Iron testing (Biolab), and indole testing (Biolab).
Carboxymethyl cellulase (CMCase) activity was determined using Dubos Salts Agar containing 0.1% carboxymethyl cellulose, as described by Rajoka and Malik [36]. After incubation at 28 ± 2 °C for 7 days, the CMCase activity was detected by flooding the agar plates with 0.1% (w/v) Congo Red solution (Merck, Darmstadt, Germany) for 30 min and rinsing with 1 M NaCl (Biolab). The presence of a clear halo around the colonies indicated CMCase activity. The cellulolytic index (CI%) was calculated using the formula proposed by Ferbiyanto et al. [37]. A similar approach was applied to detect xylanase activity, utilizing a medium containing 0.5% xylan [38].
Laccase, lignin peroxidase (LiP), and manganese peroxidase (MnP) activities were assessed following the method described by Singh et al. [39]. Briefly, Mineral Salts Medium (MSM) was prepared, containing (per liter) 1 g K2HPO4, 1 g KH2PO4, 2 g (NH4)2SO4, 0.1 g CaCl2, 0.2 g MgSO4, 0.02 g MnSO4, 0.05 g FeSO4, 5 g peptone, and 20 g agar. The medium was supplemented with 0.01% azure B, 0.01% phenol red, or 0.05% guaiacol. Sterile MSM plates were point-inoculated with the isolated bacteria and incubated at 28 ± 2 °C for 1 week. LiP and MnP activities were indicated by the discoloration of azure B and phenol red, respectively. On plates supplemented with guaiacol, laccase-positive bacteria were identified by the formation of brown-colored colonies, surrounded by a brown halo.
The pectin hydrolyzing potential of the isolates was evaluated using agar plates containing pectin [composition per liter: 5 g pectin, 5 g yeast extract, 5 g peptone, 1 g KH2PO4, 0.01 g MgSO4·7H2O, 20 g agar, and a trace element solution containing 1 g/L MnCl2·7H2O, FeSO4·7H2O, and ZnSO4∙7H2O at 1/1000 (v/v); pH 7.4]. Following incubation, the plates were flooded with trimethyl hexadecyl ammonium bromide (CTAB) solution to detect pectolysis [40]. Pectinolytic activity was quantified using the pectin degradation index, as described by Shrestha et al. [41].
Amylase activity was assessed by streaking the isolated bacteria onto Glycerol Bouillon Medium, which contained (per liter) 20 g of soluble starch, 20 mL of glycerol, 10 g of peptone, 5 g of meat extract, 3 g of CaCO3, and 15 g of agar, with a pH of 7.0. The inoculated plates were then incubated at 28 ± 2 °C for 7 days. Amylolytic activity was visualized by immersing the plates in Lugol’s solution [42].
Proteolytic activity was evaluated by streaking the isolates onto agar plates composed of the following ingredients (per liter): 28 g skim milk powder, 5 g casein enzymic hydrolysate, 2.5 g yeast extract, 1 g dextrose, and 15 g agar, with the pH adjusted to 7.0. After incubation at 28 ± 2 °C for 5–7 days, the formation of a clear halo around the colonies was observed as an indicator of protease production [43].
To detect esterase and lipase production, the bacterial isolates were inoculated onto TWEEN-20 and TWEEN-80 agar plates, respectively [44,45]. The appearance of a visible precipitate or its clearance around the colonies indicated lipolytic activity. The lipase activity index was determined as described by Ayuningrum et al. [43]. Additionally, Egg Yolk Agar was used to identify lecithinase-positive actinobacteria after incubation at 28 ± 2 °C for 7 days [46].
Gelatin hydrolysis was examined by sub-culturing the isolates on Nutrient Gelatin Agar slants. After incubation at 28 ± 2 °C for 21 days, the tubes were refrigerated for 1 h to evaluate the production of this extracellular enzyme [42].
2.4. Characterization of Plant Growth-Promoting Properties of Actinobacteria Isolates
To assess indole-3-acetic acid (IAA) production, the actinobacteria isolates were cultured in ISP-2 broth supplemented with 2% L-tryptophan (Biolab). The cultures were incubated at 28 ± 2 °C for 7 days, after which the supernatant was collected by centrifugation at 11,000 rpm for 15 min. IAA production was then quantified using a colorimetric assay, which involved mixing the supernatant with Salkowski’s reagent [0.5 M FeCl3 in 35% (w/v) HClO4], where the appearance of a pink to red color indicated auxin production [47]. The concentration of IAA produced was measured at 530 nm using a Spectroquant Pharo 100 spectrophotometer (Merck) [48].
To confirm phosphate-solubilizing activity, the isolates were inoculated onto Pikovskaya’s Agar containing Ca3(PO4)2 and incubated at 28 ± 2 °C for 7 days. The formation of a clear zone around the colonies indicated phosphate solubilization [34]. The phosphate solubilization index (PSI) was calculated as described by Boubekri et al. [49].
Siderophore production by the isolated actinobacteria was determined using the chrome azurol sulfonate (CAS) assay. The CAS reagent was prepared according to the methods of Schwyn and Neilands [50], and 100 mL of sterile reagent was mixed with 900 mL of Nutrient Agar (Sigma-Aldrich) [51]. The presence of siderophores was confirmed by the formation of an orange halo around the colonies after incubation.
Preliminary examination of diazotrophic actinobacteria was conducted using Jensen’s Agar (composition per liter: 20 g sucrose, 1 g K2HPO4, 0.5 g MgSO4, 0.5 g NaCl, 0.1 g FeSO4, 0.005 g NaMoO4, 2 g CaCO3, and 15 g agar) supplemented with 0.02% bromothymol blue. The isolates were spot-inoculated onto sterile plates and incubated at 28 ± 2 °C for 15 days.
The isolation of ammonifiers was carried out as described by Pepe et al. [52]. In brief, a medium containing 0.2 g asparagine, 1 mL trace element solution, 50 mL standard salt solution, and 950 mL distilled water (pH 6.8) was inoculated with the isolates and incubated under aerobic conditions at 28 ± 2 °C for 15 days. Ammonia production was detected by adding a few drops of Nessler’s reagent (Biolab) to the broth culture, where the development of a yellow color was considered a positive result.
Hydrogen cyanide (HCN) production was detected by cultivating the isolates on TSA supplemented with glycine (4.4 g/L). A Whatman no. 1 filter paper (Sigma-Aldrich) soaked in a solution of 0.5% picric acid and 2% sodium carbonate was placed on the lid of the inoculated Petri dish, which was then sealed with Parafilm and incubated at 28 ± 2 °C for 7 days. A change in color from yellow to orange or brown indicated HCN production.
2.5. In Vitro Antimicrobial Activity of Actinobacteria Isolates
The perpendicular streak method was utilized to assess the antibacterial activity of the isolated actinobacteria. Each isolate was streaked in parallel lines on Mueller–Hinton Agar (MHA; Biolab) and incubated at 28 ± 2 °C for 4–6 days, until a distinct actinobacterial growth line was established. Subsequently, pathogenic bacterial strains—including Agrobacterium (A.) radiobacter B.02380, Pectobacterium (P.) carotovorum subsp. carotovorum B.01109, Xanthomonas (X.) campestris B.01466, Escherichia (E.) coli ATCC 25922, Salmonella (S.) enterica subsp. enterica serovar Typhimurium ATCC 14028, Pseudomonas (Ps.) aeruginosa ATCC 27853, Staphylococcus (Staph.) aureus ATCC 6538, Bacillus (B.) cereus ATCC 11778, and Enterococcus (Ec.) faecalis ATCC 19433—were streaked perpendicular to the actinobacteria line. The plates were then incubated at 30 °C and 37 °C for an additional 24 h. The inhibitory effects were visualized and classified according to the methods of Claverías et al. [53], as follows: (−) for no inhibition, (+/−) for attenuated growth of the test strain, (+) for less than 50% growth inhibition (less than half of the bacterial line inhibited), (++) for 50% growth inhibition (half of the bacterial line inhibited), and (+++) for more than 50% growth inhibition (more than half of the bacterial line inhibited).
The inhibitory potential of the pure actinobacteria cultures against two phytopathogenic fungi, Sclerotinia (Scl.) sclerotiorum NCAIM F.00746 and Verticillium (V.) dahliae F.00734, was evaluated using a dual culture assay. Actinobacteria isolates were streaked onto Potato Dextrose Agar (PDA) plates, maintaining a 10 mm distance from the edge of the Petri dish (90-mm diameter). After a 4–6-day incubation at 28 ± 2 °C, 6 mm mycelium plugs of the fungi were placed on the opposite side of the plates, followed by further incubation at 24 ± 2 °C until the control plates (inoculated only with the phytopathogenic fungi) were fully covered by fungal growth. The inhibition rates were calculated using the formula proposed by Liu et al. [54]:
where Wi represents the width of the inhibition zone, and W is the distance between the antibacterial colony and the fungal pathogen. All isolates were tested in triplicate.
2.6. In Vitro Seed Viability Assay
A seed germination test was conducted to evaluate the effect of isolated actinobacteria on the germination of maize (Zea mays L.). Actinobacterial inocula were prepared in sterile ISP-1 broth, while maize seeds were thoroughly washed with tap water and surface-sterilized using 70% ethanol for 5 min. The seeds were then immersed in a 2% sodium hypochlorite solution for 10 min, followed by successive rinsing with sterile distilled water for 5 min. The seeds were then thoroughly dried in a sterile laminar flow chamber. The sterilized seeds were soaked in the bacterial inoculum for 2 h (150 rpm, 28 ± 2 °C) before being transferred to sterile Petri dishes containing moistened filter paper. Seeds soaked in sterile distilled water served as the control. The germination percentage and vigor index were calculated according to established protocols [48,55] using the following formulas:
where n is the number of germinated seeds after 7 days, and N is the total number of maize seeds.
2.7. Statistical Analysis
Data are presented as the mean ± standard deviation (SD) of three independent replicate analyses. Statistical significance was determined at p < 0.05 in all cases.
3. Results
3.1. Microbiological Properties of Soil Samples
Despite the cold weather conditions during sampling, the soil samples in our study demonstrated a high microbial abundance. The highest levels of culturable mesophilic microorganisms, fungi, and actinobacteria were found in the soil from the lemon balm rhizosphere (Figure 1). All samples showed a high concentration of culturable actinobacteria, ranging from 6.97 to 7.23 log10 CFU/g. However, microbial analysis revealed that these microorganisms were present in significantly lower numbers (p < 0.05) in the soil samples collected from the lavender and oregano crops. In contrast, no significant differences (p > 0.05) were observed in the counts of culturable mesophilic yeasts across the three plant species.

Figure 1.
Microorganism counts in soil samples. Values represent means ± SD from three independent observations. Means marked with different lowercase letters (a–c) within a microbial group indicate significant differences (p < 0.05).
3.2. Morphological and Physiological Characteristics of Actinobacteria Isolates
A total of 59 actinobacteria colonies were collected from the soil samples and sub-cultured on AIA plates, including 35 from the rhizospheric soil of M. officinalis L. and 12 each from the soils of L. angustifolia Mill. and O. vulgare L. Based on their enzymatic and antimicrobial properties, six strains—namely L444, M162, M241, M345, O432, and O741—were selected for further study (Figure 2).
Figure 2.
Actinobacteria isolates L444, M162, M241, M345, O432, and O741 cultivated on ISP-2 medium.
These isolates demonstrated abundant growth on all ISP media after 7 days of incubation at 28 °C, forming hard, leathery colonies with varying sizes and shapes (Table 1). On the ISP-2 plates, the isolates displayed different colors of substrate and aerial mycelia. Notably, M241 and O432 produced diffusible pigments ranging from brown to violet, while melanoid pigments were observed in L444 and O432 on ISP-6 and ISP-7 media.

Table 1.
Macroscopic characteristics of actinobacterial colonies grown on ISP-2 medium.
The tolerance of the isolates to various abiotic stresses is summarized in Table 2. The studied cultures formed colonies on ISP-2 medium across a temperature range of 20–40 °C, with an optimal growth temperature of 30 °C. Regarding pH resilience, all isolates were capable of growth within a pH range of 5.00 to 10.00, with optimal growth observed at pH 7.00. While the ideal NaCl concentration for bacterial growth was 0.00–1.00%, isolates M162, M241, M345, and O432 demonstrated the ability to grow at higher salt concentrations. However, an NaCl concentration of 7.00% inhibited growth in all isolates. Additionally, isolate O432 exhibited greater drought tolerance under in vitro conditions, as it was able to grow in a medium with an aw as low as 0.912.

Table 2.
Temperature, pH, NaCl, and drought tolerance of actinobacteria isolates.
3.3. Biochemical and Plant Growth-Promoting Properties of Actinobacteria Isolates
The biochemical analysis revealed that all actinobacteria strains were catalase-positive and oxidase-negative (Table 3). Among the six isolates, only O432 demonstrated H2S production, while none were able to utilize citrate or xylan, nor produce indole. However, all isolates synthesized urease, and two of them (M162 and M241) reduced nitrate to nitrite. Regarding CMCase activity, M241, isolated from lemon balm soil, was unable to degrade carboxymethyl cellulose as a sole carbon source. The highest CI% values were recorded for M345 (3.19 ± 0.71) and M162 (2.54 ± 0.22), whereas the CI% values for O432 and O741 (1.47 ± 0.14 and 1.64 ± 0.27, respectively) were significantly lower (p < 0.05) than those for M345. Similarly, M162 appeared to show elevated pectinase activity (2.72 ± 0.25), although no significant differences (p > 0.05) were observed among the isolates. The ligninolytic activity was qualitatively assessed: all isolates, except M345, produced LiP, while laccase production was detected only in O432, and no isolates produced MnP. Most strains were positive for amylase and protease production. Additionally, all isolates demonstrated lipase and esterase activity, with M241, M345, and O741 also showing lecithinase synthesis. Gelatin liquefaction was observed in four isolates (L444, M241, M345, and O741), indicating gelatinase production.

Table 3.
Biochemical and plant growth-promoting properties of actinobacteria isolates.
In terms of plant growth-promoting properties, the actinobacteria exhibited various beneficial mechanisms, including phosphate solubilization, nitrogen fixation, ammonia production, and the secretion of antimicrobial secondary metabolites. Three isolates (L444, O432, and O741) demonstrated inorganic phosphate solubilization, with O432 showing the highest efficiency (PSI = 3.89 ± 0.26). However, no significant differences were found among the three phosphate-solubilizing isolates.
3.4. Antimicrobial Activity of Actinobacteria Isolates
The antimicrobial potential of six actinobacterial isolates was evaluated in vitro (Table 4). During antibacterial activity screening, all isolates demonstrated antagonistic activity against at least one of the bacterial test strains. The O741 isolate was particularly effective against several foodborne and phytopathogenic bacteria, including E. coli, S. Typhimurium, A. radiobacter, Ps. aeruginosa, and X. campestris. Isolates L444 and M345 also exhibited strong inhibitory effects, effectively suppressing the growth of three and two bacterial strains, respectively. Among the tested strains, the plant pathogen A. radiobacter was the most sensitive, being inhibited by all actinobacteria isolates. In contrast, X. campestris and P. carotovorum showed minimal susceptibility to the secreted antimicrobials. The isolate with the weakest antibacterial activity (M241) was recovered from lemon balm soil. In general, Gram-negative bacteria were more sensitive to the antimicrobial compounds produced by the isolates, whereas Ec. faecalis, Staph. aureus, and B. cereus were only moderately inhibited by L444, M345, and O741.

Table 4.
Antibacterial activity of actinobacteria isolates.
As anticipated, some isolates also exhibited antifungal activity against V. dahliae and Scl. sclerotiorum. Isolate M241 demonstrated significant inhibitory effects, with inhibition rates of 46.15 ± 2.18% against Scl. sclerotiorum and 61.40 ± 3.22% against V. dahliae, compared to the results for the control. Other isolates, including M345, O432, and O741, showed weaker effects on the growth of the Verticillium wilt pathogen, with inhibition rates ranging from 12.63% to 16.84%.
3.5. Effect of Actinobacteria Isolates on Seed Germination of Zea mays (L.)
The results of the maize germination test, including germination rates and vigor indices, are summarized in Table 5. Prior to the test, bacterial compatibility was assessed using the in vitro cross-streak method [56], which confirmed no antagonistic interactions among the six isolates. The seed germination test showed that the use of sterile water or ISP-1 medium did not inhibit the germination of surface-sterilized maize seeds. Similarly, the actinobacteria treatment resulted in a germination rate of 96.67 ± 5.77%, nearly reaching the maximum possible rate. Compared to the ISP-1 treatment, the relative seed germination rate [57] using actinobacteria was 107.41%, indicating a slight improvement in maize seed germination. Additionally, the mixture of six actinobacteria significantly increased (p < 0.05) the root lengths of the treated seeds, from 27.64 ± 7.42 mm and 31.25 ± 7.64 mm in the control treatments to 54.88 ± 6.48 mm in the treated seeds. This improvement was also reflected in a significantly higher (p < 0.05) vigor index of 6248.28 ± 1661.94.

Table 5.
Effect of actinobacterial inoculant on the germination of maize (Zea mays L.) seeds.
4. Discussion
The rhizosphere is a dynamic interaction zone between the soil and the root system of medicinal and aromatic plants, characterized by an enriched mixture of nutrients and a diverse community of microorganisms [58,59]. The composition and diversity of this microbiome can vary widely, depending on factors such as plant species, soil characteristics, microbial interactions, and applied soil management practices [60,61]. Notably, members of the Lamiaceae family, including Melissa, Lavandula, and Origanum species, have been traditionally used for medicinal purposes [62,63,64]. Beyond their medicinal uses, these plants are also integral to cultivation techniques such as crop rotation, and their botanicals (e.g., terpenoids, phenolic compounds) and byproducts obtained from the herbal industry can be recycled as biopesticides or organic soil amendments. This practice can improve the physical, chemical, and biological properties of agricultural soils, both directly and indirectly. Moreover, these herbs influence the composition of soil microbial communities by releasing root exudates that stimulate the growth of unique fungal and bacterial species near the roots, thus contributing to plant nutrition and disease management [20,60].
Actinobacteria have been extensively studied regarding their critical role in carbon cycling and their potent antimicrobial properties [18,65]. As a primary habitat, soil can contain up to 106–109 actinobacterial cells per gram [66]. In this study, the cultivable microbial composition of rhizospheric soils from the examined medicinal plants varied considerably, but all samples exhibited elevated levels of mesophilic actinobacteria. However, the concentration of bacteria in the rhizosphere primarily depends on soil nutritional factors, soil type, and plant species [60]. Consistent with our findings, Zharkova et al. [25] reported Actinobacteriota as the prevailing phylum in rhizospheric samples from aromatic crops such as Thymus (T.) vulgaris L., Mentha × piperita L., Salvia officinalis L., O. vulgare L., and T. serpillum L. Similarly, Adamović et al. [60] identified actinomycetes in the rhizospheres of basil, mint, dill, and marigold. Furthermore, rhizospheric soils of Ocimum (Oc.) sanctum L., Oc. basilicum L., Marrubium vulgare L., M. officinalis L., O. syriacum L., T. vulgaris L., and Majorana hortensis L. were found to be extensively colonized by actinomycetes [21,67]. Additionally, Castronovo et al. [62] isolated Agromyces spp. and Arthrobacter spp. from O. vulgare soil, while Emiliani et al. [63] reported the presence of actinobacteria in the rhizosphere of L. angustifolia Mill., although absent from internal root tissues. Similarly, Tamilarasi et al. [68] observed higher microbial counts (heterotrophic bacteria, actinomycetes, and fungi) in the rhizospheric soil of locally available medicinal plants compared to those noted in the non-rhizospheric soil. Among the isolated actinobacteria, Streptomyces spp. were predominant, followed by Deuteromycetes spp. and Frankia spp.
In recent decades, soil health has been compromised by intensive agricultural practices and the overuse of synthetic pesticides and fertilizers. There is a growing need for environmentally sustainable methods to enhance soil fertility and improve crop yields. To this end, the use of multifunctional microorganisms as biofertilizers offers a promising alternative to stimulate plant growth and protect against biotic and abiotic stresses [4,69]. Once inoculated into the soil, actinobacteria can colonize root systems and survive under hostile conditions [18]. However, their effectiveness relies on suitable environmental conditions, such as the appropriate pH and temperature for metabolism [5]. In the present study, all isolated strains were mesophilic, exhibiting moderate to robust growth across a pH range of 5.00 to 10.00, with an optimal pH of 7.00. Similar findings were reported by Messaoudi et al. [70], where isolates from saline environments and the rhizosphere of date palms showed optimal growth at pH 7.0. Although a saline concentration of 7.00% (w/v) inhibited all actinobacteria, some isolates (M162, M241, M345, and O432) displayed slight halotolerance, growing in a medium with a NaCl concentration of 6.00% (w/v) [71]. Typically, bacteria prefer higher aw values for optimal growth, with most requiring a minimum aw of 0.900. Among the isolated actinobacteria, O432 demonstrated the ability to grow under water-stressed conditions at an aw level as low as 0.912, indicating its xerotolerance [34].
In addition to their physiological properties, the production of extracellular enzymes enhances the survival of actinobacteria in competitive environments [72]. These microbes are renowned for producing a diverse array of biotechnologically significant enzymes [73] that can hydrolyze complex compounds. Lignocellulose, a major component of plant biomass, represents a crucial carbon reservoir in terrestrial ecosystems [74]. While cellulose degradation is primarily associated with Basidiomycota and Ascomycota, bacteria also play a key role in breaking down cellulosic materials [75]. Both fungi and actinobacteria are pivotal in lignin decomposition [74], a process driven by enzymes such as MnP, LiP, and laccase [9]. In this study, most of the isolated actinobacteria produced cellulase, laccase, and LiP (83.3%, 16.7%, and 83.3% of isolates, respectively) in vitro, suggesting their potential to accelerate the decomposition of lignocellulosic plant material in soil. Notably, strain O432 was capable of producing all three enzymes. Although xylanase is essential for the degradation of xylan, a major component of hemicellulose [76], none of the isolated actinobacteria produced xylanase. However, positive results were obtained for the hydrolysis of pectin and soluble starch, as well as for the production of esterase, lipase, lecithinase, gelatinase, urease, and nitrate reductase. The detected proteases may also play a role in controlling phytopathogenic fungi by compromising cell wall integrity [77].
Certain bacteria, including actinobacteria, exhibit plant growth-promoting potential through various mechanisms. For example, they can fix atmospheric nitrogen, synthesize antimicrobial compounds, produce soluble iron complexes, generate phytohormones (e.g., indole-acetic acid, cytokinins, gibberellins, 1-aminocyclopropane-1-carboxylic acid), and solubilize inorganic phosphates [48]. In this study, three strains (L444, O432, and O741) demonstrated phosphate-solubilizing capabilities, with PSI values of 2.48 ± 0.11, 2.44 ± 0.13, and 2.12 ± 0.49, respectively. Additionally, all isolates were able to grow under nitrogen-free conditions, and ammonia production was observed in one strain (M345). Numerous studies have documented similar beneficial effects of plant growth-promoting rhizobacteria [49,78]. From a practical perspective, these microbes could serve as bioinoculants, offering an eco-friendly alternative to chemical fertilizers by supplying essential micro- and macronutrients through phosphorus solubilization and nitrogen fixation [78,79,80]. However, none of the isolates showed the ability to produce IAA, siderophores, or HCN.
Regarding the microbial safety of agricultural products, several factors can compromise their microbiological integrity throughout the farm-to-fork continuum. Pre-harvest hazards are particularly critical because once pathogen contamination occurs in the field, decontamination becomes challenging [2]. Plant-beneficial microorganisms, particularly those colonizing plant roots, can secrete antibiotics that inhibit pathogen growth [81]. Actinobacteria, in particular, are known for producing structurally diverse and bioactive compounds [82], with approximately 10,000 such compounds identified to date [81]. In this study, all six actinobacteria isolates exhibited antibacterial activity against at least one of the tested pathogenic strains, with 83.3% inhibiting the growth of two or more pathogens. Notably, the isolates actively inhibited Gram-negative pathogens, including A. radiobacter, E. coli, Ps. aeruginosa, and S. typhimurium. However, Gram-positive bacteria were less sensitive to the antibacterial effects of these isolates. While previous studies have reported that rhizospheric actinobacteria are generally more active against Gram-positive bacteria [83,84], in this study, the least sensitive strains were two phytopathogens, P. carotovorum and X. campestris. These findings are consistent with those of Jeffrey et al. [85], who observed that only 2 out of 212 actinomycete strains exhibited antagonistic activity against X. campestris. Similarly, Djebaili et al. [86] reported that only 5 out of 14 actinomycete strains showed moderate to high activity against P. carotovorum. Moreover, endophytic microbes may be more effective than rhizospheric strains due to their ability to colonize plants and promote growth [87]. Among the isolates, L444, M345, O432, and O741 demonstrated broad antibacterial activity, while M241 exhibited the weakest inhibition against most tested pathogens. Interestingly, M241 showed the strongest antifungal activity against both phytopathogens, with inhibition rates exceeding 45%. Generally, these microbes protect plant roots by inhibiting fungal pathogen development through the production of antifungal compounds and enzymes [88].
Finally, considering that seed germination is a critical phase in the crop life cycle, directly impacting subsequent growth and overall plant fitness [55], the effect of the actinobacterial inoculant on maize germination was evaluated under in vitro conditions. Although the mixture of isolated strains did not significantly affect germination rates, it did enhance shoot and root development, leading to a significantly higher vigor index.
5. Conclusions
The six actinobacteria strains isolated from the rhizospheres of lavender, lemon balm, and oregano showed significant bioactive potential. They exhibited key enzymatic activities, including cellulase, laccase, and LiP, vital for lignocellulose degradation. The strains also promoted plant growth through phosphate solubilization, nitrogen fixation, and improved maize seed germination. Furthermore, they demonstrated antimicrobial activity against A. radiobacter and V. dahliae, with inhibition rates exceeding 45%, in some cases. These findings suggest that the strains could be effective microbial inoculants for improving soil health, promoting plant growth, and controlling soil-borne diseases in sustainable agriculture.
Author Contributions
Conceptualization, B.G., A.S., V.K., E.L. and L.V.; methodology, B.G., A.S., B.Á. and V.K.; formal analysis, L.V.; investigation, B.G., B.Á. and A.S.; resources, B.G. and A.S.; writing—original draft preparation, B.G. and A.S.; writing—review and editing, L.V.; supervision, E.L. and L.V.; project administration, E.L.; funding acquisition, B.G. All authors have read and agreed to the published version of the manuscript.
Funding
This research was supported by Project No. 2019-2-1.1.-EUREKA-2020-00011 and Project No. 2023-2.1.2-KDP-2023-00017, the latter funded by the Ministry of Culture and Innovation of Hungary through the National Research, Development, and Innovation Fund under the KDP-2023 funding scheme.
Institutional Review Board Statement
Not applicable.
Data Availability Statement
The data are contained within the article. Further inquiries can be directed to the corresponding author.
Conflicts of Interest
Author A.S. is currently employed by a commercial company, Kisalföldi Agricultural Ltd. The other authors declare no commercial or financial relationships that could be perceived as a potential conflict of interest in relation to this research. The funders had no role in the design of the study; in the collection, analyses, or interpretation of data; in the writing of the manuscript; or in the decision to publish the results.
References
- Rickson, R.J.; Deeks, L.K.; Graves, A.; Harris, J.A.H.; Kibblewhite, M.G.; Sakrabani, R. Input constraints to food production: The impact of soil degradation. Food Secur. 2015, 7, 351–364. [Google Scholar] [CrossRef]
- Alegbeleye, O.O.; Singleton, I.; Sant’Ana, A.S. Sources and contamination routes of microbial pathogens to fresh produce during field cultivation: A review. Food Microbiol. 2018, 73, 177–208. [Google Scholar] [CrossRef] [PubMed]
- Boubekri, K.; Soumare, A.; Mardad, I.; Lyamlouli, K.; Ouhdouch, Y.; Hafidi, M.; Kouisni, L. Multifunctional role of actinobacteria in agricultural production sustainability: A review. Microbiol. Res. 2022, 261, 127059. [Google Scholar] [CrossRef]
- Mitra, D.; Mondal, R.; Khoshru, B.; Senapati, A.; Radha, T.K.; Mahakur, B.; Uniyal, N.; Myo, E.M.; Boutaj, H.; Sierra, B.E.G.; et al. Actinobacteria-enhanced plant growth, nutrient acquisition, and crop protection: Advances in soil, plant, and microbial multifactorial interactions. Pedosphere 2022, 32, 149–170. [Google Scholar] [CrossRef]
- Singh, J.S.; Pandey, V.C.; Singh, D.P. Efficient soil microorganisms: A new dimension for sustainable agriculture and environmental development. Agric. Ecosyst. Environ. 2011, 140, 339–353. [Google Scholar] [CrossRef]
- Sundström, J.F.; Albihn, A.; Boqvist, S.; Ljungvall, K.; Marstorp, H.; Martiin, C.; Nyberg, K.; Vågsholm, I.; Yuen, J.; Magnusson, U. Future threats to agricultural food production posed by environmental degradation, climate change, and animal and plant diseases—A risk analysis in three economic and climate settings. Food Secur. 2014, 6, 201–215. [Google Scholar] [CrossRef]
- Bao, Y.; Dolfing, J.; Guo, Z.; Chen, R.; Wu, M.; Li, Z.; Lin, X.; Feng, Y. Important ecophysiological roles of non-dominant actinobacteria in plant residue decomposition, especially in less fertile soils. Microbiome 2021, 9, 84. [Google Scholar] [CrossRef] [PubMed]
- Gaind, S.; Nain, L. Chemical and biological properties of wheat soil in response to paddy straw incorporation and its biodegradation by fungal inoculants. Biodegradation 2007, 18, 495–503. [Google Scholar] [CrossRef]
- Sharma, S.; Kumawat, K.C.; Kaur, P.; Kaur, S.; Gupta, N. Crop Residue heterogeneity: Decomposition by potential indigenous ligno-cellulolytic microbes and enzymatic profiling. Curr. Res. Microb. Sci. 2024, 6, 100227. [Google Scholar] [CrossRef]
- Yao, C.; Guo, H.; Xu, H.; Yang, X.; Yao, Z.; Gu, J. Maize stalk incorporation increases N2O emissions that offset the benefit of SOC sequestration in a winter wheat-summer maize field: A four-year measurement in long-term fertilizer experiments. Agric. Ecosyst. Environ. 2023, 352, 108507. [Google Scholar] [CrossRef]
- Welbaum, G.E.; Sturz, A.V.; Dong, Z.; Nowak, J. Managing soil microorganisms to improve productivity of agro-ecosystems. Crit. Rev. Plant Sci. 2004, 23, 175–193. [Google Scholar] [CrossRef]
- Lee, S.-M.; Kong, H.G.; Song, G.C.; Ryu, C.-M. Disruption of Firmicutes and actinobacteria abundance in tomato rhizosphere causes the incidence of bacterial wilt disease. ISME J. 2021, 15, 330–347. [Google Scholar] [CrossRef] [PubMed]
- Javed, Z.; Tripathi, G.D.; Mishra, M.; Dashora, K. Actinomycetes—The microbial machinery for the organic-cycling, plant growth, and sustainable soil health. Biocatal. Agric. Biotechnol. 2021, 31, 101893. [Google Scholar] [CrossRef]
- Ye, J.; Zou, R.; Zhou, D.; Deng, X.; Wu, N.; Chen, D.; Xu, J. Insights into the phylogenetic diversity, biological activities, and biosynthetic potential of mangrove rhizosphere actinobacteria from Hainan Island. Front. Microbiol. 2023, 14, 1157601. [Google Scholar] [CrossRef]
- Golinska, P.; Wypij, M.; Agarkar, G.; Rathod, D.; Dahm, H.; Rai, M. Endophytic actinobacteria of medicinal plants: Diversity and bioactivity. Antonie Van Leeuwenhoek 2015, 108, 267–289. [Google Scholar] [CrossRef]
- Rangseekaew, P.; Pathom-aree, W. Cave actinobacteria as producers of bioactive metabolites. Front. Microbiol. 2019, 10, 387. [Google Scholar] [CrossRef]
- Beskrovnaya, P.; Sexton, D.L.; Golmohammadzadeh, M.; Hashimi, A.; Tocheva, E.I. Structural, Metabolic and Evolutionary Comparison of Bacterial Endospore and Exospore Formation. Front. Microbiol. 2021, 12, 630573. [Google Scholar] [CrossRef]
- Anwar, S.; Ali, B.; Sajid, I. Screening of rhizospheric actinomycetes for various in-vitro and in-vivo plant growth promoting (PGP) traits and for agroactive compounds. Front. Microbiol. 2016, 7, 1334. [Google Scholar] [CrossRef]
- Solans, M.; Pelliza, Y.I.; Tadey, M. Inoculation with native actinobacteria may improve desert plant growth and survival with potential use for restoration practices. Microb. Ecol. 2022, 83, 380–392. [Google Scholar] [CrossRef]
- Greff, B.; Sáhó, A.; Lakatos, E.; Varga, L. Biocontrol activity of aromatic and medicinal plants and their bioactive components against soil-borne pathogens. Plants 2023, 12, 706. [Google Scholar] [CrossRef]
- Karthikeyan, B.; Jaleel, C.A.; Lakshmanan, G.M.A.; Deiveekasundaram, M. Studies on rhizosphere microbial diversity of some commercially important medicinal plants. Colloids Surf. B Biointerfaces 2008, 62, 143–145. [Google Scholar] [CrossRef] [PubMed]
- Shaikh, M.; Mokat, D. Role of Rhizosphere Fungi Associated with Commercially Explored Medicinal and Aromatic Plants: A Review. Curr. Agric. Res. J. 2018, 6, 72–77. [Google Scholar] [CrossRef]
- Tiwari, S.; Pandey, R.; Gross, A. Identification of Rhizospheric Microorganisms That Manages Root Knot Nematode and Improve Oil Yield in Sweet Basil (Ocimum basilicum L.). Agronomy 2021, 11, 570. [Google Scholar] [CrossRef]
- Steinberger, Y.; Doniger, T.; Sherman, C.; Jeyaraman, M.; Applebaum, I. Soil Bacterial Community of Medicinal Plant Rhizosphere in a Mediterranean System. Agriculture 2024, 14, 664. [Google Scholar] [CrossRef]
- Zharkova, E.K.; Vankova, A.A.; Selitskaya, O.V.; Malankina, E.L.; Drenova, N.V.; Zhelezova, A.D.; Khlyustov, V.K.; Belopukhov, S.L.; Zhevnerov, A.V.; Sviridova, L.A.; et al. Bacterial communities of Lamiacea L. Medicinal Plants: Structural features and rhizosphere effect. Microorganisms 2023, 11, 197. [Google Scholar] [CrossRef]
- Szűcs, G. Környezeti Vizsgálat és Értékelés (Environmental Assessment and Evaluation)—Nagyszentjános Község (Nagyszentjános Village). Available online: https://nagyszentjanos.asp.lgov.hu/sites/nagyszentjanos/files/imce/2022-12/3_kornyezeti-vizsgalat.pdf (accessed on 1 October 2024).
- Williams, S.T.; Cross, T. Chapter XI Actinomycetes. In Methods in Microbiology; Booth, C., Ed.; Academic Press: Cambridge, MA, USA, 1971; Volume 4, pp. 295–334. [Google Scholar] [CrossRef]
- Menasria, T.; Monteoliva-Sánchez, M.; Benhadj, M.; Benammar, L.; Boukoucha, M.; Aguilera, M. Unraveling the enzymatic and antibacterial potential of rare halophilic actinomycetes from Algerian hypersaline wetland ecosystems. J. Basic Microbiol. 2022, 62, 1202–1215. [Google Scholar] [CrossRef] [PubMed]
- Niladevi, K.N.; Prema, P. Mangrove actinomycetes as the source of ligninolytic enzymes. Actinomycetologica 2005, 19, 40–47. [Google Scholar] [CrossRef]
- Shirling, E.B.; Gottlieb, D. Methods for Characterization of Streptomyces Species. Int. J. Syst. Evol. Microbiol. 1966, 16, 313–340. [Google Scholar] [CrossRef]
- Chaudhary, H.S.; Yadav, J.; Shrivastava, A.R.; Singh, S.; Singh, A.K.; Gopalan, N. Antibacterial activity of actinomycetes isolated from different soil samples of Sheopur (a city of Central India). J. Adv. Pharm. Technol. Res. 2013, 4, 118–123. [Google Scholar] [CrossRef]
- Meena, B.; Anburajan, L.; Johnthini, M.A.; Vinithkumar, N.V.; Dharani, G. Exploration of mangrove-associated actinobacteria from South Andaman Islands, India. Syst. Microbiol. Biomanufacturing 2023, 3, 702–718. [Google Scholar] [CrossRef]
- Hazarika, S.N.; Saikia, K.; Thakur, D. Characterization and selection of endophytic actinobacteria for growth and disease management of tea (Camellia sinensis L.). Front. Plant Sci. 2022, 13, 989794. [Google Scholar] [CrossRef] [PubMed]
- Lasudee, K.; Tokuyama, S.; Lumyong, S.; Pathom-aree, W. Actinobacteria associated with arbuscular mycorrhizal Funneliformis mosseae spores, taxonomic characterization and their beneficial traits to plants: Evidence obtained from mung bean (Vigna radiata) and Thai jasmine rice (Oryza sativa). Front. Microbiol. 2018, 9, 1247. [Google Scholar] [CrossRef] [PubMed]
- Hallsworth, J.E.; Nomura, Y.; Iwahara, M. Ethanol-induced water stress and fungal growth. J. Ferment. Bioeng. 1998, 86, 451–456. [Google Scholar] [CrossRef]
- Rajoka, M.I.; Malik, K.A. Cellulase Production by Cellulomonas biazotea cultured in media containing different cellulosic substrates. Bioresour. Technol. 1997, 59, 21–27. [Google Scholar] [CrossRef]
- Ferbiyanto, A.; Rusmana, I.; Raffiudin, R. Characterization and identification of cellulolytic bacteria from gut of worker Macrotermes gilvus. HAYATI J. Biosci. 2015, 22, 197–200. [Google Scholar] [CrossRef]
- Woo, H.L.; Hazen, T.C.; Simmons, B.A.; DeAngelis, K.M. Enzyme Activities of aerobic lignocellulolytic bacteria isolated from wet tropical forest soils. Syst. Appl. Microbiol. 2014, 37, 60–67. [Google Scholar] [CrossRef]
- Singh, A.; Kumar, R.; Maurya, A.; Chowdhary, P.; Raj, A. Isolation of functional ligninolytic Bacillus aryabhattai from paper mill sludge and its lignin degradation potential. Biotechnol. Rep. 2022, 35, e00755. [Google Scholar] [CrossRef]
- Saoudi, B.; Habbeche, A.; Kerouaz, B.; Haberra, S.; Ben Romdhane, Z.; Tichati, L.; Boudelaa, M.; Belghith, H.; Gargouri, A.; Ladjama, A. Purification and characterization of a new thermoalkaliphilic pectate lyase from Actinomadura keratinilytica Cpt20. Process Biochem. 2015, 50, 2259–2266. [Google Scholar] [CrossRef]
- Shrestha, S.; Khatiwada, J.R.; Zhang, X.; Chio, C.; Kognou, A.L.M.; Chen, F.; Han, S.; Chen, X.; Qin, W. Screening and molecular identification of novel pectinolytic bacteria from forest soil. Fermentation 2021, 7, 40. [Google Scholar] [CrossRef]
- Djebaili, R.; Pellegrini, M.; Smati, M.; Del Gallo, M.; Kitouni, M. Actinomycete strains isolated from saline soils: Plant-growth-promoting traits and inoculation effects on Solanum lycopersicum. Sustainability 2020, 12, 4617. [Google Scholar] [CrossRef]
- Ayuningrum, D.; Sabdaningsih, A.; Jati, O.E. The Potential of phylogenetically diverse culturable actinobacteria from Litopenaeus vannamei pond sediment as extracellular proteolytic and lipolytic enzyme producers. Trop. Life Sci. Res. 2022, 33, 165–192. [Google Scholar] [CrossRef] [PubMed]
- Gopinath, S.C.B.; Hilda, A.; Anbu, P. Extracellular enzymatic activity profiles in fungi isolated from oil-rich environments. Mycoscience 2005, 46, 119–126. [Google Scholar] [CrossRef]
- Ramnath, L.; Sithole, B.; Govinden, R. Identification of lipolytic enzymes isolated from bacteria indigenous to Eucalyptus wood species for application in the pulping industry. Biotechnol. Rep. 2017, 15, 114–124. [Google Scholar] [CrossRef] [PubMed]
- Hmani, I.; Ktari, L.; Ismail, A.; EL Bour, M. Biotechnological potential of Ulva ohnoi epiphytic bacteria: Enzyme production and antimicrobial activities. Front. Mar. Sci. 2023, 10, 1042527. [Google Scholar] [CrossRef]
- Chaiya, L.; Kumla, J.; Suwannarach, N.; Kiatsiriroat, T.; Lumyong, S. Isolation, Characterization, and efficacy of actinobacteria associated with arbuscular mycorrhizal spores in promoting plant growth of chili (Capsicum flutescens L.). Microorganisms 2021, 9, 1274. [Google Scholar] [CrossRef]
- Chukwuneme, C.F.; Babalola, O.O.; Kutu, F.R.; Ojuederie, O.B. Characterization of actinomycetes isolates for plant growth promoting traits and their effects on drought tolerance in maize. J. Plant Interact. 2020, 15, 93–105. [Google Scholar] [CrossRef]
- Boubekri, K.; Soumare, A.; Mardad, I.; Lyamlouli, K.; Hafidi, M.; Ouhdouch, Y.; Kouisni, L. The screening of potassium- and phosphate-solubilizing actinobacteria and the assessment of their ability to promote wheat growth parameters. Microorganisms 2021, 9, 470. [Google Scholar] [CrossRef]
- Schwyn, B.; Neilands, J.B. Universal Chemical Assay for the Detection and Determination of Siderophores. Anal. Biochem. 1987, 160, 47–56. [Google Scholar] [CrossRef]
- Sharma, P.; Aswini, K.; Sai Prasad, J.; Kumar, N.; Pathak, D.; Gond, S.; Venkadasamy, G.; Suman, A. Characterization of actinobacteria from wheat seeds for plant growth promoting traits and protection against fungal pathogens. J. Basic Microbiol. 2023, 63, 439–453. [Google Scholar] [CrossRef]
- Pepe, O.; Ventorino, V.; Blaiotta, G. Dynamic of functional microbial groups during mesophilic composting of agro-industrial wastes and free-living (N2)-fixing bacteria application. Waste Manag. 2013, 33, 1616–1625. [Google Scholar] [CrossRef]
- Claverías, F.P.; Undabarrena, A.N.; González, M.; Seeger, M.; Cámara, B.P. Culturable diversity and antimicrobial activity of actinobacteria from marine sediments in Valparaíso Bay, Chile. Front. Microbiol. 2015, 6, 737. [Google Scholar] [CrossRef]
- Liu, C.; Zhuang, X.; Yu, Z.; Wang, Z.; Wang, Y.; Guo, X.; Xiang, W.; Huang, S. Community structures and antifungal activity of root-associated endophytic actinobacteria of healthy and diseased soybean. Microorganisms 2019, 7, 243. [Google Scholar] [CrossRef] [PubMed]
- Selvakumar, G.; Bhatt, R.M.; Upreti, K.K.; Bindu, G.H.; Shweta, K. Citricoccus zhacaiensis B-4 (MTCC 12119) a novel osmotolerant plant growth promoting actinobacterium enhances onion (Allium cepa L.) seed germination under osmotic stress conditions. World J. Microbiol. Biotechnol. 2015, 31, 833–839. [Google Scholar] [CrossRef] [PubMed]
- Al-Daghari, D.S.S.; Al-Sadi, A.M.; Al-Mahmooli, I.H.; Janke, R.; Velazhahan, R. Biological Control Efficacy of Indigenous Antagonistic Bacteria Isolated from the Rhizosphere of Cabbage Grown in Biofumigated Soil against Pythium aphanidermatum Damping-Off of Cucumber. Agriculture 2023, 13, 626. [Google Scholar] [CrossRef]
- Fiodor, A.; Ajijah, N.; Dziewit, L.; Pranaw, K. Biopriming of Seed with Plant Growth-Promoting Bacteria for Improved Germination and Seedling Growth. Front. Microbiol. 2023, 14, 1142966. [Google Scholar] [CrossRef]
- Oberhofer, M.; Hess, J.; Leutgeb, M.; Gössnitzer, F.; Rattei, T.; Wawrosch, C.; Zotchev, S.B. Exploring actinobacteria associated with rhizosphere and endosphere of the native Alpine medicinal plant Leontopodium nivale subspecies alpinum. Front. Microbiol. 2019, 10, 2531. [Google Scholar] [CrossRef]
- Applebaum, I.; Jeyaraman, M.; Sherman, C.; Doniger, T.; Steinberger, Y. Structure and function of the soil rhizosphere fungal communities in medicinal plants—A preliminary study. Agriculture 2022, 12, 152. [Google Scholar] [CrossRef]
- Adamović, D.; Đalović, I.; Mrkovački, N. Microbial abundance in rhizosphere of medicinal and aromatic plant species in conventional and organic growing systems. Ratar. Povrt. 2015, 52, 1–6. [Google Scholar] [CrossRef]
- Zu, M.; Yuan, Y.; Zuo, J.; Sun, L.; Tao, J. Microbiota associated with the rhizosphere of Paeonia lactiflora Pall. (ornamental cultivar). Appl. Soil Ecol. 2022, 169, 104214. [Google Scholar] [CrossRef]
- Castronovo, L.M.; Calonico, C.; Ascrizzi, R.; Del Duca, S.; Delfino, V.; Chioccioli, S.; Vassallo, A.; Strozza, I.; De Leo, M.; Biffi, S.; et al. The cultivable bacterial microbiota associated to the medicinal plant Origanum vulgare L.: From antibiotic resistance to growth-inhibitory properties. Front. Microbiol. 2020, 11, 862. [Google Scholar] [CrossRef]
- Emiliani, G.; Mengoni, A.; Maida, I.; Perrin, E.; Chiellini, C.; Fondi, M.; Gallo, E.; Gori, L.; Maggini, V.; Vannacci, A.; et al. Linking bacterial endophytic communities to essential oils: Clues from Lavandula angustifolia Mill. Evid. Based Complement. Altern. Med. 2014, 2014, 650905. [Google Scholar] [CrossRef] [PubMed]
- Greff, B.; Lakatos, E.; Szigeti, J.; Varga, L. Co-composting with herbal wastes: Potential effects of essential oil residues on microbial pathogens during composting. Crit. Rev. Environ. Sci. Technol. 2021, 51, 457–511. [Google Scholar] [CrossRef]
- Araujo, R.; Gupta, V.V.S.R.; Reith, F.; Bissett, A.; Mele, P.; Franco, C.M.M. Biogeography and emerging significance of actinobacteria in Australia and Northern Antarctica soils. Soil Biol. Biochem. 2020, 146, 107805. [Google Scholar] [CrossRef]
- Gohain, A.; Manpoong, C.; Saikia, R.; De Mandal, S. Actinobacteria: Diversity and biotechnological applications. In Recent Advancements in Microbial Diversity; De Mandal, S., Bhatt, P., Eds.; Academic Press: London, UK; Elsevier: Amsterdam, The Netherlands, 2020; pp. 217–231. ISBN 978-0-12-821265-3. [Google Scholar] [CrossRef]
- Ahmed, E.A.; Hassan, E.A.; Tobgy, K.M.K.E.; Ramadan, E.M. Evaluation of rhizobacteria of some medicinal plants for plant growth promotion and biological control. Ann. Agric. Sci. 2014, 59, 273–280. [Google Scholar] [CrossRef]
- Tamilarasi, S.; Nanthakumar, K.; Karthikeyan, K.; Lakshmanaperumalsamy, P. Diversity of root associated microorganisms of selected medicinal plants and influence of rhizomicroorganisms on the antimicrobial property of Coriandrum sativum. J. Environ. Biol. 2008, 29, 127–134. [Google Scholar]
- Faddetta, T.; Polito, G.; Abbate, L.; Alibrandi, P.; Zerbo, M.; Caldiero, C.; Reina, C.; Puccio, G.; Vaccaro, E.; Abenavoli, M.R.; et al. Bioactive metabolite survey of actinobacteria showing plant growth promoting traits to develop novel biofertilizers. Metabolites 2023, 13, 374. [Google Scholar] [CrossRef]
- Messaoudi, O.; Wink, J.; Bendahou, M. Diversity of actinobacteria isolated from date palms rhizosphere and saline environments: Isolation, identification and biological activity evaluation. Microorganisms 2020, 8, 1853. [Google Scholar] [CrossRef] [PubMed]
- Reang, L.; Bhatt, S.; Tomar, R.S.; Joshi, K.; Padhiyar, S.; Vyas, U.M.; Kheni, J.K. Plant growth promoting characteristics of halophilic and halotolerant bacteria isolated from coastal regions of Saurashtra Gujarat. Sci. Rep. 2022, 12, 4699. [Google Scholar] [CrossRef]
- Ahmed, M.M.; Hagagy, N.; AbdElgawad, H. Establishment of actinobacteria–Satureja hortensis interactions under future climate CO2-enhanced Crop productivity in drought environments of Saudi Arabia. Environ. Sci. Pollut. Res. 2021, 28, 62853–62867. [Google Scholar] [CrossRef]
- Hamdi, C.; Arous, F.; Boudagga, S.; Harrath, N.; Nwodo, U.; Jaouani, A. Actinobacteria isolated from Tunisian forest soils show high diversity and biotechnological potential. Biologia 2023, 78, 3653–3665. [Google Scholar] [CrossRef]
- Větrovský, T.; Steffen, K.T.; Baldrian, P. Potential of cometabolic transformation of polysaccharides and lignin in lignocellulose by soil actinobacteria. PLoS ONE 2014, 9, e89108. [Google Scholar] [CrossRef] [PubMed]
- Shamshitov, A.; Decorosi, F.; Viti, C.; Fornasier, F.; Kadžienė, G.; Supronienė, S. Characterisation of cellulolytic bacteria isolated from agricultural soil in Central Lithuania. Sustainability 2023, 15, 598. [Google Scholar] [CrossRef]
- Wei, Y.; Wu, D.; Wei, D.; Zhao, Y.; Wu, J.; Xie, X.; Zhang, R.; Wei, Z. Improved lignocellulose-degrading performance during straw composting from diverse sources with actinomycetes inoculation by regulating the key enzyme activities. Bioresour. Technol. 2019, 271, 66–74. [Google Scholar] [CrossRef]
- Song, J.; Sun, X.; Luo, X.; He, C.; Huang, Z.; Zhao, J.; He, B.; Du, X.; Wang, X.; Xiang, W. Actinoplanes aureus sp. nov., a novel protease-producing actinobacterium isolated from soil. Antonie Van Leeuwenhoek 2021, 114, 1517–1527. [Google Scholar] [CrossRef]
- Nafis, A.; Raklami, A.; Bechtaoui, N.; El Khalloufi, F.; El Alaoui, A.; Glick, B.R.; Hafidi, M.; Kouisni, L.; Ouhdouch, Y.; Hassani, L. Actinobacteria from extreme niches in Morocco and their plant growth-promoting potentials. Diversity 2019, 11, 139. [Google Scholar] [CrossRef]
- Boukhatem, Z.F.; Merabet, C.; Tsaki, H. Plant growth promoting actinobacteria, the most promising candidates as bioinoculants? Front. Agron. 2022, 4, 849911. [Google Scholar] [CrossRef]
- Chouyia, F.E.; Romano, I.; Fechtali, T.; Fagnano, M.; Fiorentino, N.; Visconti, D.; Idbella, M.; Ventorino, V.; Pepe, O. P-solubilizing Streptomyces roseocinereus MS1B15 with multiple plant growth-promoting traits enhance barley development and regulate rhizosphere microbial population. Front. Plant Sci. 2020, 11, 1137. [Google Scholar] [CrossRef] [PubMed]
- Palaniyandi, S.A.; Yang, S.H.; Zhang, L.; Suh, J.-W. Effects of actinobacteria on plant disease suppression and growth promotion. Appl. Microbiol. Biotechnol. 2013, 97, 9621–9636. [Google Scholar] [CrossRef]
- Li, F.; Liu, S.; Lu, Q.; Zheng, H.; Osterman, I.A.; Lukyanov, D.A.; Sergiev, P.V.; Dontsova, O.A.; Liu, S.; Ye, J.; et al. Studies on antibacterial activity and diversity of cultivable actinobacteria isolated from mangrove soil in Futian and Maoweihai of China. Evid. Based Complement. Altern. Med. 2019, 2019, 3476567. [Google Scholar] [CrossRef]
- Kachor, A.; Tistechok, S.; Rebets, Y.; Fedorenko, V.; Gromyko, O. bacterial community and culturable actinomycetes of Phyllostachys viridiglaucescens rhizosphere. Antonie Van Leeuwenhoek 2024, 117, 9. [Google Scholar] [CrossRef]
- Tistechok, S.; Skvortsova, M.; Mytsyk, Y.; Fedorenko, V.; Parnikoza, I.; Luzhetskyy, A.; Gromyko, O. The Diversity and antibacterial activity of culturable actinobacteria isolated from the rhizosphere soil of Deschampsia antarctica (Galindez Island, maritime Antarctic). Polar Biol. 2021, 44, 1859–1868. [Google Scholar] [CrossRef]
- Jeffrey, L.S.H.; Sahilah, A.M.; Son, R.; Tosiah, S. Isolation and screening of actinomycetes from Malaysian soil for their enzymatic and antimicrobial activities. J. Trop. Agric. Food Sci. 2007, 35, 159–164. [Google Scholar]
- Djebaili, R.; Pellegrini, M.; Bernardi, M.; Smati, M.; Kitouni, M.; Del Gallo, M. Biocontrol Activity of Actinomycetes Strains against Fungal and Bacterial Pathogens of Solanum lycopersicum L. and Daucus carota L.: In Vitro and In Planta Antagonistic Activity. Biol. Life Sci. Forum 2020, 4, 27. [Google Scholar] [CrossRef]
- Mingma, R.; Pathom-aree, W.; Trakulnaleamsai, S.; Thamchaipenet, A.; Duangmal, K. Isolation of rhizospheric and roots endophytic actinomycetes from Leguminosae plant and their activities to inhibit soybean pathogen, Xanthomonas campestris pv. glycine. World J. Microbiol. Biotechnol. 2014, 30, 271–280. [Google Scholar] [CrossRef]
- Thampi, A.; Bhai, R.S. Rhizosphere actinobacteria for combating Phytophthora capsici and Sclerotium rolfsii, the major soil borne pathogens of black pepper (Piper nigrum L.). Biol. Control 2017, 109, 1–13. [Google Scholar] [CrossRef]
Disclaimer/Publisher’s Note: The statements, opinions and data contained in all publications are solely those of the individual author(s) and contributor(s) and not of MDPI and/or the editor(s). MDPI and/or the editor(s) disclaim responsibility for any injury to people or property resulting from any ideas, methods, instructions or products referred to in the content. |
© 2024 by the authors. Licensee MDPI, Basel, Switzerland. This article is an open access article distributed under the terms and conditions of the Creative Commons Attribution (CC BY) license (https://creativecommons.org/licenses/by/4.0/).